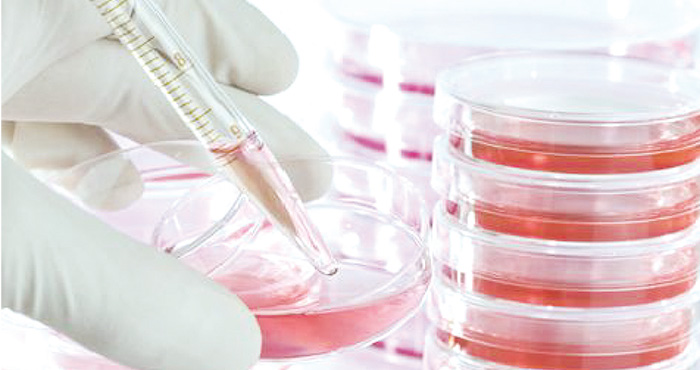

教宗談罕見疾病日 呼籲給病人平等機會
期數
3970
刊登日期
2020.03.20
主曆
主曆 2020 年 03 月 22 日 四旬期第四主日
(綜合梵蒂岡新聞訊)教宗方濟各於二月廿九日「罕見疾病日」發表的推文,籲請世人共同促使病人享有平等的機會和圓滿的生命。當天,聖座促進人類整體發展部部長圖爾克森樞機(Peter Turkson)也發表訊息,呼籲國際社會支持並幫助罕見疾病患者。
教宗發推文指出:「罕見疾病日給我們提供了一個機會一同照顧患病的弟兄姐妹,把研究、醫療和社會救濟整合起來,使他們享有平等的機會和圓滿的生命」。
今年罕見疾病日活動的主題與公平及獲得平等的機會有關,為使病患的潛能得以發揮。對此,聖座促進人類整體發展部部長圖爾克森樞機呼籲國際社會關懷罕見疾病患者。
全球三億人患罕見疾病
圖爾克森樞機在訊息中首先指出,全球有三億人患有罕見疾病,對此情形絕不能忽視,而要給予關注。樞機接著表示,罕見疾病通常很難診斷,而且患者的家庭無助地生活在鄙視和孤獨中;而在那些衛生系統非常單薄的國家,情形更加嚴重。
圖爾克森樞機強調,在罕見疾病中,科學研究發揮著重要作用。他指出,「科學知識和制藥業的研究即使要遵守各自的某些法律,例如保護知識產權和為研發提供支持的合理利潤,它們必須在法律和診斷以及給予基本治療上找到適當的平衡,特別對於罕見疾病的案例」。
對於幫助最脆弱的患病兒童,歐洲最大的臨床及研究型兒童醫院— —羅馬耶穌聖嬰醫院二月廿七日與信息技術公司IBM就共享醫療知識和尖端技術達成合作協議,以加速對患有嚴重疾病的兒童患者的診斷和治療。此項合作的目標,是開發一個能夠將基因、臨床和實驗室信息與人工智能整合在一起的數據庫。

廣告






















